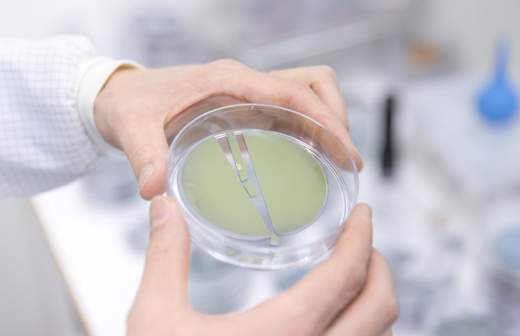

- Статьи
- Science and technology
- Universal selection: new human species and space robots with tentacles
Universal selection: new human species and space robots with tentacles

American and Chinese scientists have discovered a previously unknown human species, while their Russian colleagues have discovered new antibiotics in the body of an antelope. Read about it, as well as about the tests of a robot with tentacles on the ISS, a biomolecule that will protect healthy cells during radiation therapy, and a method of studying the memory of the universe in the rating of science news for the week, prepared by Izvestia.
New antibiotics found in the body of antelopes
Russian scientists have discovered a new class of antimicrobial peptides in the body of antelopes. The study involved employees of SIC "Kurchatov Institute" (including the Department of Molecular and Radiation Biophysics SIC "KI" - PJIF), Lomonosov Moscow State University and the Institute of Bioorganic Chemistry named after Academicians M.M. Shemyakin and Y.A. Ovchinnikov.
Peptides in living organisms perform the function of building material. They are chains of amino acids that make up proteins. The discovered new class was named "rumidicins" (from the Latin word that means "ruminants"). These substances in the animals' bodies protect them from bacteria.
- In the genotype of ruminants there are areas that are responsible for the production of antimicrobial peptides. They consist of three dozen amino acids. These peptides disrupt in microbial cells the work of ribosomes - molecular complexes that synthesize proteins and deliver them into the cell through the output peptide channel. Rumicidin "climbs" into this channel and causes plugging of the ribosome. It also disrupts the very process of protein synthesis in the ribosome," said Elena Polesskova, a senior researcher at the Department of Molecular and Radiation Biophysics of the Kurchatov Institute Research Center, PIAR - JINRF Elena Polesskova.
According to the scientists, the study of rumicidins is important because they are able to bypass the defense mechanisms of bacteria. Also, these peptides are non-toxic, easily synthesized and have a high speed of action. Their effectiveness for therapy and the absence of side effects experts have confirmed on animals.
Biomolecules will protect healthy tissues during radiation therapy
Nanoparticles that protect healthy cells from death during radiation therapy of cancerous tumors have been synthesized by scientists from the Institute of Theoretical and Experimental Biophysics of the Russian Academy of Sciences (Pushchino) and the N.G. Chernyshevsky Saratov National Research State University.
According to experts, the new particles are based on cerium oxide - a compound of rare-earth metal and oxygen, which enters into a large number of redox reactions. The efficiency of the compound was improved by attaching to it pyrroloquinolinquinone - a biomolecule that has an antioxidant effect and is involved in the regulation of mitochondria (cellular "power plants").
- Due to its properties, the nanoparticles activate the antioxidant systems of normal cells, and in cancer cells, on the contrary, stimulate the production of destructive reactive oxygen species. Probably, the effect is related to the different acidity of healthy and pathogenic cells, - said the project leader, leading researcher, head of the laboratory of isotope studies ITEB RAS Nelly Popova.
The development may be useful for reducing the radiation load during radiation therapy, experts believe. It will reduce the negative impact on healthy cells.
Unmanned vehicles with tentacles tested on the ISS
A flying robot with tentacle manipulators has been tested on the International Space Station. This device Astrobee ("star bee") - one of three robotic systems that NASA developed five years ago to assist astronauts.
The difference between the apparatus and its terrestrial counterparts is that it functions in weightlessness. The robot has a cubic shape with a width of edges of just over 30 centimeters. To move the apparatus uses jet mini-motors.
It is assumed that the drone can perform various tasks, including observing experiments and performing simple operations. The vehicles can also self-recharge. They function both individually and as part of a swarm.
In tests for the first time in space conditions tested installed on one of the robots tentacles-manipulators. "Flexible hands" are equipped with adhesive pads that give the robots the ability to pick up objects, carry them from place to place. They also allow them to attach to walls to save energy.
In the future, as the project develops, Astrobee robots will be able to service spacecraft and help them maneuver.
The discovery of a new species of homo will help to clarify the ancient species of humans
Scientists from the University of Hawaii (Honolulu, USA) and the Institute of Vertebrate Paleontology and Paleoanthropology (Beijing, China), systematizing fossil remains, came to the conclusion that may have discovered a new species of man.
In total, archaeologists identified the remains of 16 people who belonged to this species. As noted in the study, these people were characterized by large head sizes - had large skulls and teeth. The new species was named Homo juluensis (translated from Latin - "big-headed man").
As experts suggest, Homo juluensis appeared about 300 thousand years ago in East Asia. They hunted in small groups, made stone tools and possibly clothing and capes from animal skins. The population disappeared about 50,000 years ago.
According to scientists, attributing the findings to a new species helped innovative ways of systematizing fossil finds.
- The study helps explain the remains, which for various reasons can not be attributed to the already known Homo erectus, Homo neanderthalensis or Homo sapiens- said one of the authors of the scientific work, a professor at the University of Hawaii Christopher Bae. - Although the project began several years ago, we did not expect to be able to propose a new species of hominid (human ancestor).
The researcher specified that the discovery will help to better fill in the gaps in the history of human evolution in Asia and around the globe.
Scientists have found a way to "open" the memory of the universe
A team of astrophysicists from the U.S., Sweden and Poland has proposed a way to identify weak gravitational waves (fluctuations of space and time), which can not yet be identified by known means. The method is based on the observation of deformations that are caused by supernovae flares.
In a paper on the study, the scientists modeled the collapse (supernova outbreak) of three stars that, prior to their demise, had masses comparable to 10, 15, and 25 solar masses. As a result, they made an idea of what kind of weak gravitational waves should arise at that moment. In their opinion, at the moment of birth of a supernova increases the period of oscillation of space and time.
As explained by scientists, it is believed that it is weak gravitational waves forever retain the "memory" of events that occur in space. If you learn to "read" them, you can restore the history of the evolution of the universe.
Thus, according to the researchers' conclusions, the detection of anomalous gravitational fluctuations can point to astronomical events that occurred in ancient times. Also, the proposed method can confirm Einstein's general theory of relativity - a hypothesis that underlies modern ideas about the universe.
Переведено сервисом «Яндекс Переводчик»